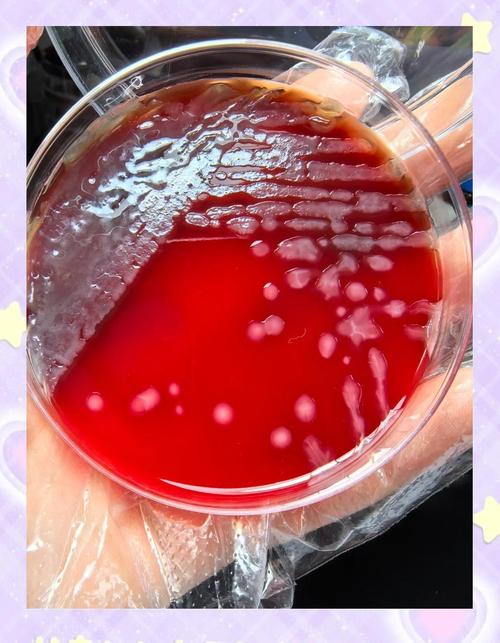
口腔铜绿假单胞菌感染有何危害与应对?

口腔铜绿假单胞菌感染有何危害与应对?
核心摘要
口腔铜绿假单胞菌(Pseudomonas aeruginosa)感染通常不是健康人群的常见口腔问题,它更多是一种机会性感染,这意味着它主要在宿主免疫力低下、口腔环境被破坏(如长期使用抗生素、口腔卫生极差)或存在局部创伤时才会“趁虚而入”,由于其强大的耐药性,一旦感染,治疗起来会比较棘手。
(图片来源网络,侵删)
什么是铜绿假单胞菌?
- 俗称:绿脓杆菌。
- 特点:
- 广泛存在:是一种常见的环境细菌,存在于土壤、水、植物表面,甚至医院环境中。
- 机会主义致病菌:对健康人通常无害,但对免疫力低下的人是致命的威胁。
- 耐药性强:天生对多种抗生素不敏感,容易产生耐药性,是医院感染的主要病原体之一。
- 特征性表现:感染的组织或分泌物常带有一种特殊的、略带甜味的“鼠尿味”或“绿脓味”,并且会产生蓝绿色的色素(绿脓素),这是其名称的由来。
为什么会发生口腔感染?(高危因素)
健康人的口腔菌群会抑制铜绿假单胞菌的生长,以下情况会打破这种平衡,使其大量繁殖并引发感染:
-
免疫力低下:
- HIV/AIDS 患者:特别是 CD4 细胞计数很低时。
- 癌症患者:正在接受化疗或放疗,导致免疫系统被抑制。
- 器官移植后:长期服用抗排异药物(免疫抑制剂)。
- 糖尿病患者:血糖控制不佳时,身体抵抗力下降。
- 长期使用皮质类固醇的患者。
-
口腔屏障被破坏:
- 口腔卫生极度不良:牙结石、菌斑堆积,为细菌提供了温床。
- 严重的口腔黏膜损伤:如物理创伤(咬伤、烫伤)、化学灼伤(误食腐蚀性物质)、放射治疗引起的口腔黏膜炎。
- 长期佩戴义齿或正畸矫治器:如果清洁不彻底,义齿基托下方或矫治器周围容易藏污纳垢。
-
局部因素:
(图片来源网络,侵删)- 根管治疗失败:根管系统复杂,铜绿假单胞菌容易在其中定植,是导致根管治疗失败和根尖周炎的常见原因之一。
- 颌面部骨髓炎或深部脓肿:细菌在坏死组织中繁殖。
- 长期使用抗生素:广谱抗生素会杀死口腔内正常的益生菌,导致菌群失调,为铜绿假单胞菌的生长腾出空间。
-
医院内感染:
- 气管插管:破坏了呼吸道天然屏障。
- 口腔护理不当:在重症监护室,如果口腔清洁做得不好,患者容易发生口腔铜绿假单胞菌感染。
临床表现(症状)
口腔铜绿假单胞菌感染的症状多种多样,取决于感染的位置和严重程度:
-
最常见的表现:坏死性口炎
- 剧烈疼痛:疼痛感非常明显,远超普通溃疡。
- 组织坏死:牙龈、颊黏膜、舌等部位出现灰黑色、边缘清晰的坏死组织,轻轻一碰就出血或脱落。
- 伪膜形成:表面覆盖一层灰白色或黄绿色的假膜。
- 特殊气味:口腔有明显的腐臭味或“绿脓味”。
- 流涎:因疼痛和口腔清洁困难,患者可能流口水。
-
其他表现:
(图片来源网络,侵删)- 根尖周炎:表现为持续性、搏动性疼痛,牙齿有浮起感,牙龈上可能反复长“脓包”,常规根管治疗无效。
- 颌面部蜂窝织炎:面部肿胀、发红、发热、疼痛,严重时可导致张口困难,甚至引发败血症。
- 舌炎或唇炎:舌部或唇部出现肿胀、红斑、糜烂,甚至溃疡。
如何诊断?
医生通常会结合以下方式进行诊断:
- 临床观察:根据典型的症状(如坏死性病变、特殊气味)做出初步判断。
- 微生物学检查(金标准):
- 涂片镜检:从感染部位(如坏死组织、脓液)取样,在显微镜下观察是否为革兰氏阴性杆菌。
- 细菌培养:将样本接种在培养基上进行培养,如果长出蓝绿色的菌落,即可确诊,药敏试验是至关重要的一步,用于指导后续的抗生素选择。
- 影像学检查:
- 对于怀疑有根尖周炎或颌骨骨髓炎的患者,会进行X光片或CBCT(锥形束CT)检查,观察牙根或颌骨的破坏情况。
如何治疗?
治疗是综合性的,需要多管齐下:
-
局部治疗(基础且重要):
- 彻底清创:清除坏死的组织和牙结石,这是控制感染的第一步。
- 抗菌漱口水:
- 12%氯己定(洗必泰)漱口水:能有效抑制口腔细菌。
- 3%过氧化氢溶液(双氧水):有氧化和杀菌作用,尤其对厌氧菌效果好,常与氯己定交替使用。
- 聚维酮碘漱口水:广谱杀菌剂。
- 局部用药:对于局部溃疡,可涂抹含有抗生素的药膏。
-
全身治疗(关键):
- 抗生素:必须在医生指导下使用,且必须基于药敏试验结果。
- 常用药物:
- 抗假单胞菌青霉素类:如哌拉西林/他唑巴坦。
- 第三代或第四代头孢菌素:如头孢他啶、头孢吡肟。
- 碳青霉烯类:如亚胺培南、美罗培南(重症感染首选)。
- 氨基糖苷类:如阿米卡星(常需与其他药物联合使用)。
- 喹诺酮类:如环丙沙星、左氧氟沙星(部分情况下有效)。
- 疗程:通常需要足够长的疗程(1-2周或更长),以防复发和产生耐药性。
-
支持治疗:
- 增强免疫力:积极治疗原发病(如控制血糖、改善营养)。
- 疼痛管理:使用止痛药物缓解剧烈疼痛。
- 口腔卫生指导:教育患者如何正确清洁口腔,尤其是在使用义齿或矫治器的情况下。
预后
- 早期发现、及时治疗:对于免疫力正常、感染局限于口腔表层的患者,预后通常良好。
- 高危人群:对于免疫力严重低下的患者,感染可能迅速扩散,发展为全身性感染(如败血症、脓毒血症),死亡率极高。
- 耐药性问题:如果抗生素使用不当,细菌可能产生多重耐药,导致治疗失败,预后变差。
如何预防?
- 保持良好的口腔卫生:这是最根本的预防措施,每天至少刷牙两次,使用牙线,定期洗牙。
- 及时处理口腔问题:如有牙痛、牙龈出血、口腔溃疡等问题,应及时就医,不要拖延。
- 合理使用抗生素:不要自行购买和滥用抗生素,应在医生指导下使用。
- 增强全身抵抗力:均衡饮食、规律作息、适度锻炼、控制慢性病(如糖尿病)。
- 高危人群需特别注意:免疫力低下者应更加注重口腔护理,并定期进行口腔检查。
口腔铜绿假单胞菌感染虽然凶险,但并非不可战胜,关键在于提高警惕,对于有高危因素的人群,一旦出现口腔异常的剧烈疼痛、坏死和组织,应立即就医,医生会通过专业的诊断和药敏试验,制定出最有效的治疗方案。
文章版权及转载声明
作者:99ANYc3cd6本文地址:https://www.schc.com.cn/post/6903.html发布于 今天
文章转载或复制请以超链接形式并注明出处世康健康网